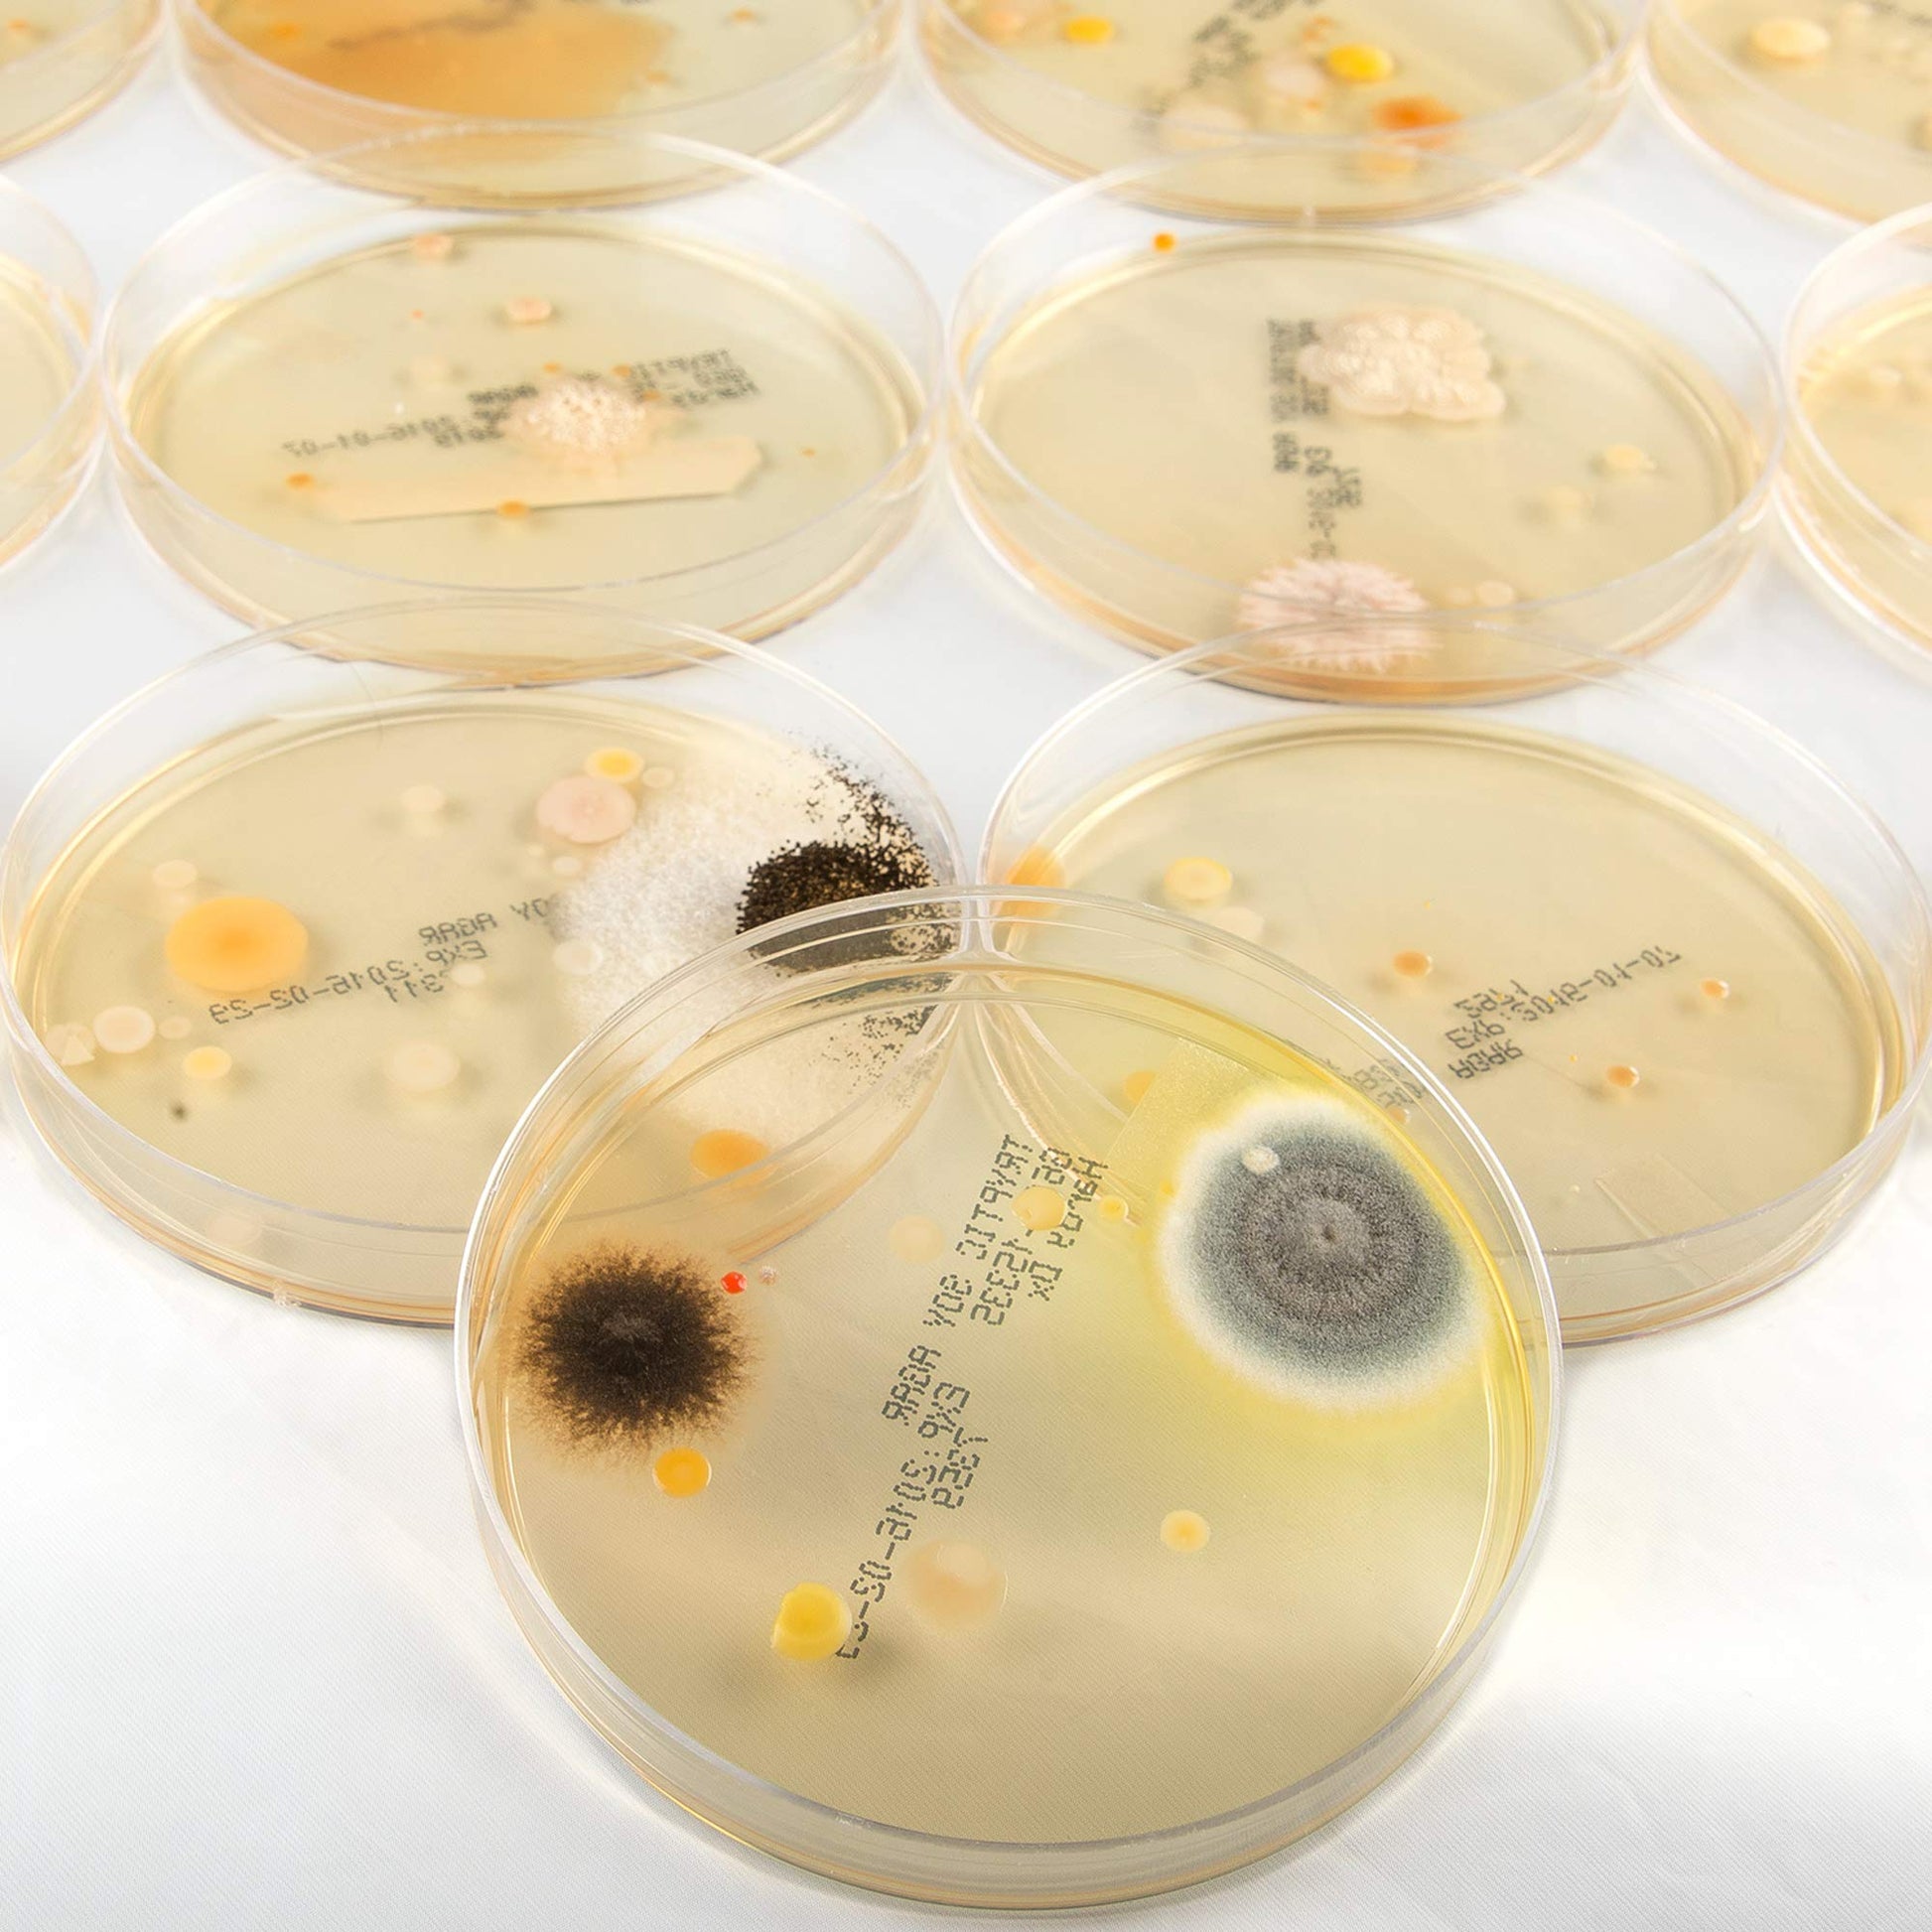

You will not be allowed to compare more than 4 products at a time
View compareFrequently Asked Questions
- Q: What materials are included in the Growing Bacteria Science Experiment Kit? A: The kit includes plastic petri dishes, cotton swabs, and a microwave-safe plastic beaker, along with easy-to-make nutrient agar.
- Q: What are the dimensions of the Growing Bacteria Science Experiment Kit? A: The kit has a length of one inch, a width of one inch, and a height of one inch.
- Q: Is the Growing Bacteria Science Experiment Kit suitable for children? A: Yes, the kit is designed for young scientists and is popular for science fairs, making it suitable for children.
- Q: How do you use the Growing Bacteria Science Experiment Kit? A: To use the kit, prepare the nutrient agar, place swabs in the petri dishes, and follow the included activity guide to design your experiment.
- Q: What age group is recommended for the Growing Bacteria Science Experiment Kit? A: The kit is recommended for children ages eight and older, as it allows for both simple and advanced experiments.
- Q: Can the Growing Bacteria Science Experiment Kit be used in schools? A: Yes, the kit is ideal for classroom settings, particularly for science fairs and teaching the scientific method.
- Q: How should you care for the Growing Bacteria Science Experiment Kit? A: Keep the kit in a cool, dry place and ensure all components are cleaned after use, especially the petri dishes.
- Q: Is the Growing Bacteria Science Experiment Kit safe to store? A: Yes, the kit is safe to store as long as it is kept away from direct sunlight and moisture.
- Q: What safety precautions should be taken when using the kit? A: Always wash hands after handling the kit and avoid direct contact with any bacteria that may grow during experiments.
- Q: How do I dispose of materials from the Growing Bacteria Science Experiment Kit? A: Dispose of used agar and petri dishes according to local waste disposal regulations, preferably in a sealed bag.
- Q: How does the Growing Bacteria Science Experiment Kit compare to other science kits? A: This kit is unique for its focus on microbiology, offering hands-on experience with nutrient agar, unlike many other kits.
- Q: Is the Growing Bacteria Science Experiment Kit appropriate for beginners? A: Yes, the kit is designed for beginners and includes a step-by-step guide to help users understand the scientific method.
- Q: What if the Growing Bacteria Science Experiment Kit arrives damaged? A: If the kit arrives damaged, contact customer support for assistance with returns or replacements.
- Q: Does the Growing Bacteria Science Experiment Kit come with a warranty? A: Yes, the kit typically includes a manufacturer's warranty; check the packaging for details.
- Q: How can I enhance the experiment using the Growing Bacteria Science Experiment Kit? A: You can enhance your experiments by exploring different variables, such as using various surfaces for swabbing.
- Q: What is the best way to clean the components of the Growing Bacteria Science Experiment Kit? A: Clean the petri dishes and beaker with warm, soapy water, and rinse thoroughly before storage.